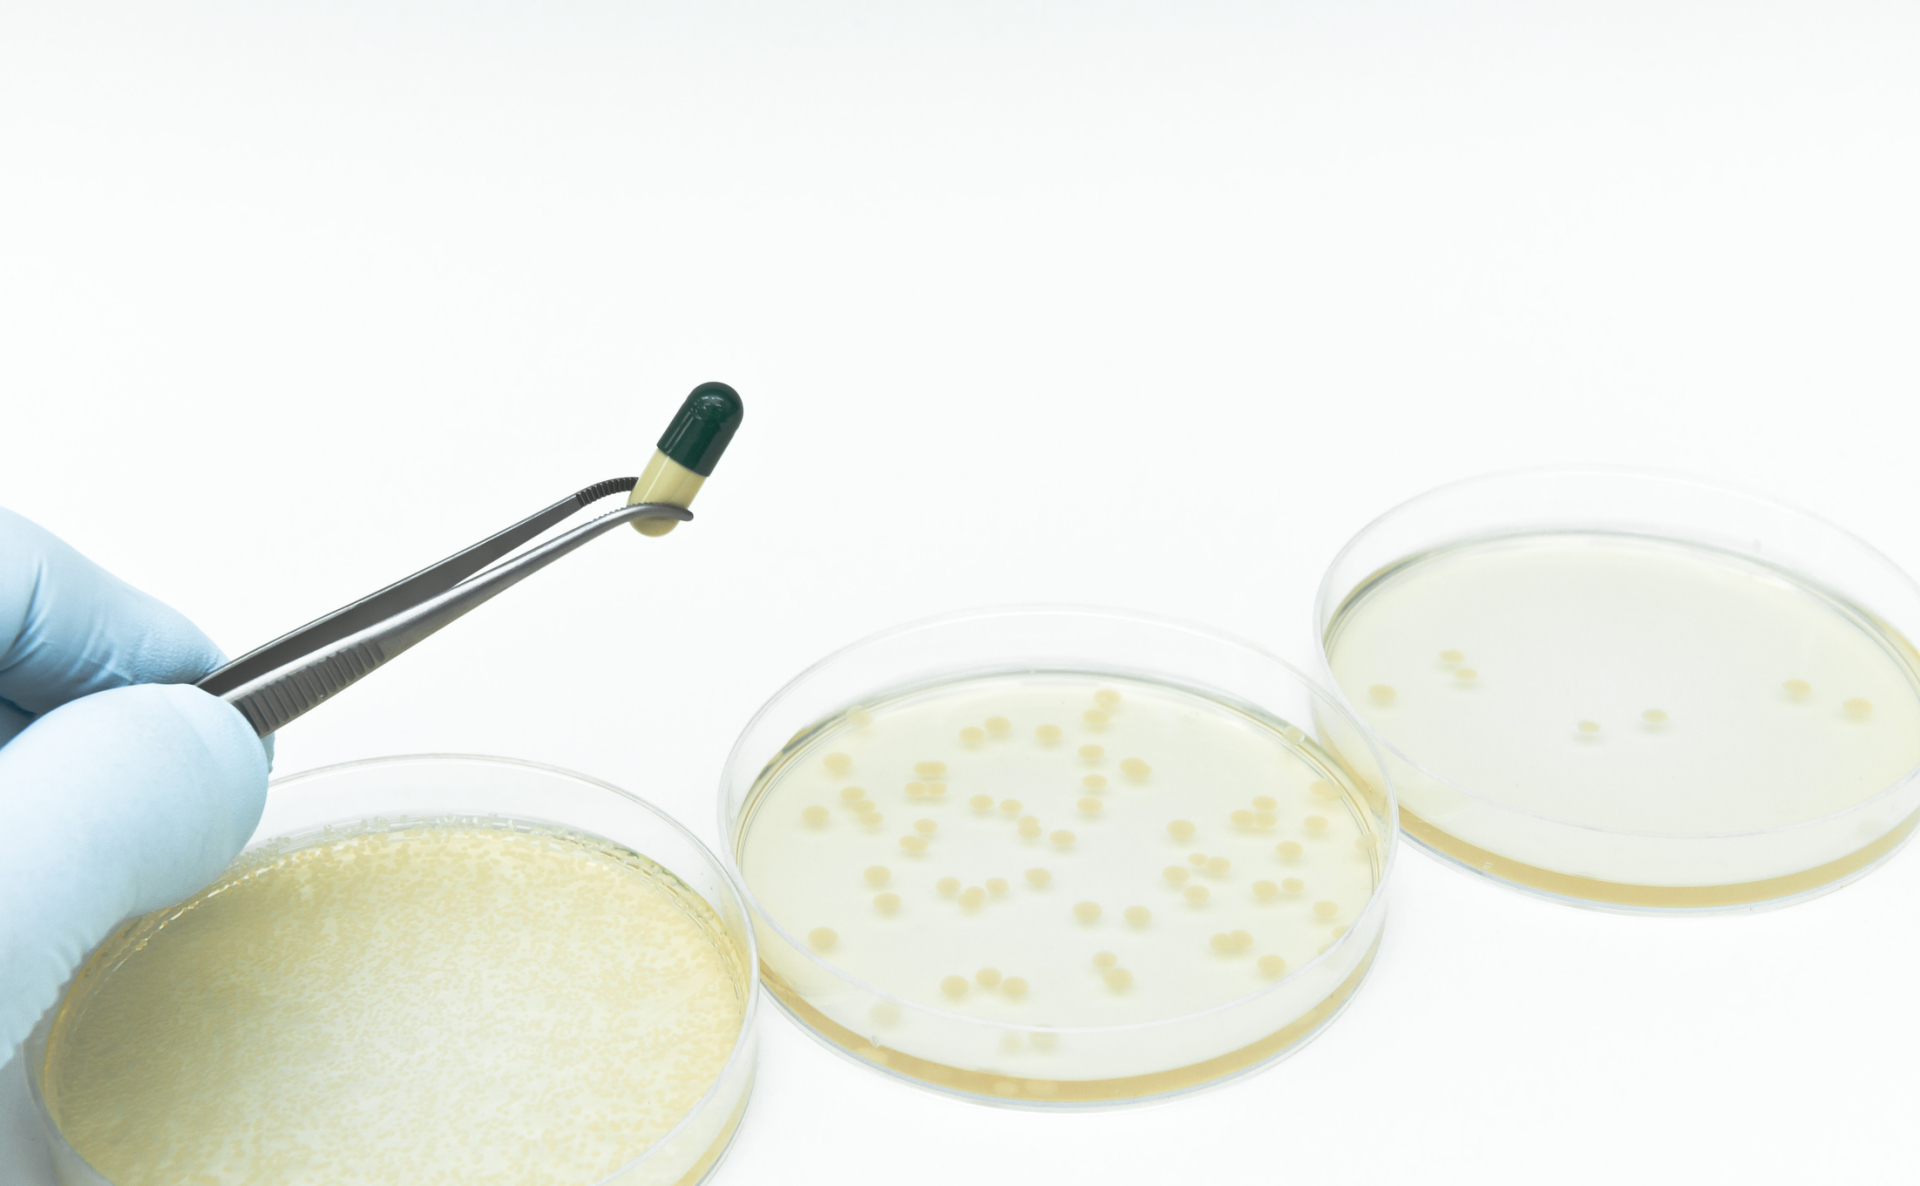

Analys av bioburden - totalantalsbestämning

Bakgrund
Uttrycket bioburden används för att beskriva hur mycket mikroorganismer det finns på eller i en medicinteknisk produkt eller ett sterilt barriärsystem. Bioburden visar summan av mikroorganismer från olika källor inklusive råmaterial, tillverkningsprocesser, rengöring, förpackning och annat som kommer i kontakt med produkten. Bioburdenanalyser sker bland annat vid:
- Vid validering av steriliseringsprocesser
- Rutinkontroll av tillverkningsprocesser
- Kontroll av råmaterial, produktkomponenter och förpackning
- Bedömning av rengöringsmetoders effektivitet
- Övergripande program för miljökontroll
Metoder
Stora krav ställs på hanteringen av proverna då man varken får introducera nya mikroorganismer eller ha ihjäl de som eventuellt finns i vätskan eller på ytan innan analysen har genomförts. Micans tillämpar beprövade metoder och har strikta rutiner i laboratoriet för att säkerställa största möjliga reproducerbarhet i provhanteringen, vilket garanteras av vår ackreditering enligt ISO 17025:2018 för mikrobiologiska studier, Micans laboratorium följer OECD:s principer för god laboratoriepraxis (GLP), ENV / MC / CHEM (98) 17.
Micans analyserar bioburden genom kvantitativ bestämning av antal viabla mikroorganismer; aeroba bakterier, jäst och mögel. Vi tar fram en anpassad metod som först valideras med olika mikroorganismer; vissa metoder kräver även att en korrektionsfaktor bestäms. När mikroorganismer påträffas kan vi erbjuda karaktärisering av påträffade mikrober.
Micans analyserar bioburden åt kunder som bland annat tillverkar förbandsmaterial, linser, i produkter för in vitro fertilisering, keramiska och metalliska implantat samt probiotica. Kundnöjdheten är mycket hög bland annat eftersom våra kunder kan göra auditioner på plats i vårt laboratorium och medverka i utformningen av sina bioburdenanalyser. Hos Micans är kundrelationerna personliga och alltid öppna för diskussion, förslag och frågor.
Uppdragen utförs enligt:
- SS-EN ISO 11737-1:2018 Sterilisering av medicintekniska produkter – Mikrobiologiska metoder – Del 1: Skattning av antalet mikroorganismer på produkter,
- USP <61> Microbiological examination of nonsterile products - Microbial enumeration tests
- EP 2.6.12 Microbiological examination of non-sterile products: Microbial enumeration tests
Kontakta oss på analys@micans.se för prisuppgift.
Micans laboratorium är:
ISO 17025: 2018 (SS) ackrediterad av Swedac (id 10351)
ISO 9001: 2015 certifierad av A3 cert (id 1565)
ISO 14001: 2015 certifierad av A3 cert (id 1565)
För detaljer, se Kvalitet och miljö
Micans laboratorium följer OECD: s principer för god laboratoriepraxis (GLP), ENV / MC / CHEM (98) 17


